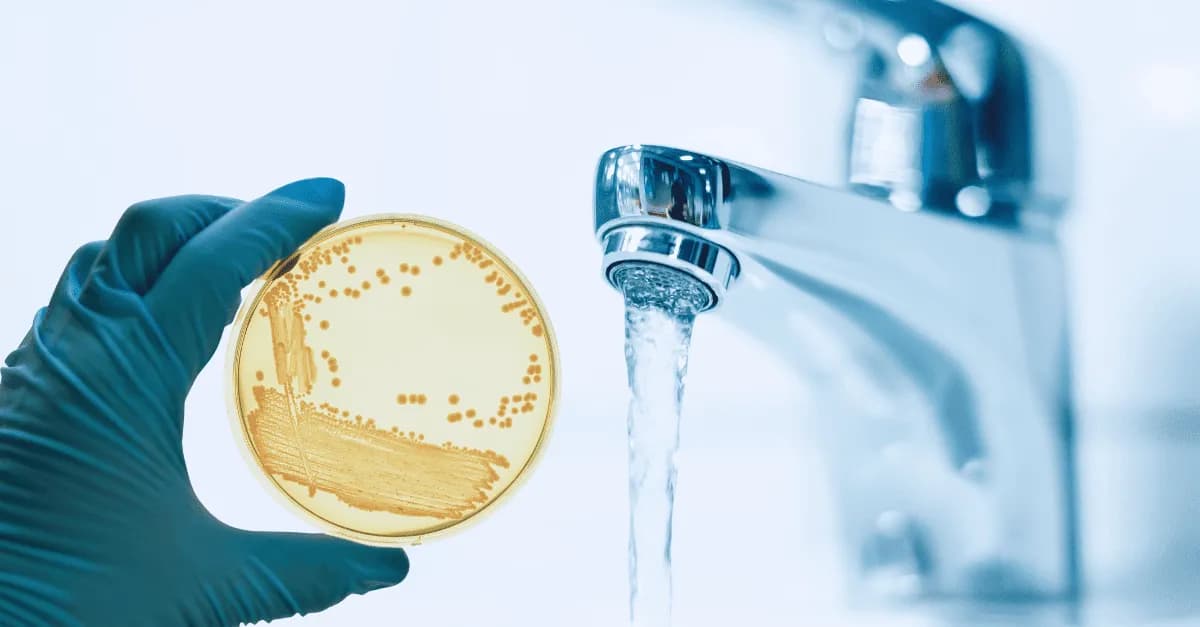
Czy woda w pociągu jest zdatna do picia? Co powinieneś wiedzieć Czy woda w pociągu jest zdatna do picia? Co powinieneś wiedzieć

Czy woda w pociągu jest zdatna do picia? To pytanie nurtuje wielu podróżnych, zwłaszcza w kontekście komfortu i bezpieczeństwa podczas podróży. Woda z kranu w pociągach Amtrak jest zazwyczaj uznawana za zdatną do picia, jednak niektórzy pasażerowie zalecają, aby jej unikać i zamiast tego zabrać własną wodę. W szczególności w czasach pandemii, kiedy obawy o zdrowie są na czołowej pozycji, warto przyjrzeć się tej kwestii bliżej.
W artykule omówimy standardy dotyczące jakości wody w pociągach oraz potencjalne zagrożenia związane z jej piciem. Przedstawimy również opinie pasażerów oraz zalecenia dotyczące zabierania własnej wody w podróż. Naszym celem jest dostarczenie rzetelnych informacji, które pomogą w podjęciu świadomej decyzji podczas podróży pociągiem.
Kluczowe informacje:- Woda z kranu w pociągach Amtrak jest zazwyczaj zdatna do picia, ale niektórzy pasażerowie sugerują ostrożność.
- Warto zabrać własną wodę, zwłaszcza w czasach pandemii, aby zminimalizować ryzyko zdrowotne.
- Standardy jakości wody w pociągach są regulowane przez odpowiednie instytucje, ale mogą się różnić w zależności od przewoźnika.
- Opinie pasażerów na temat jakości wody w pociągach są zróżnicowane, co sugeruje, że doświadczenia mogą być subiektywne.
- Alternatywy dla wody w pociągach, takie jak napoje butelkowane, są dostępne, ale mogą być droższe.
Czy woda w pociągu jest zdatna do picia? Sprawdź fakty
Woda w pociągach budzi wiele pytań wśród podróżnych, szczególnie w kontekście bezpieczeństwa jej spożycia. Wiele osób zastanawia się, czy woda w pociągu jest zdatna do picia oraz jakie standardy jakości obowiązują w tym zakresie. W przypadku pociągów Amtrak, woda z kranu jest zazwyczaj uznawana za bezpieczną, jednak niektórzy pasażerowie sugerują, aby jej unikać i zamiast tego zabrać własną wodę, zwłaszcza w czasach pandemii.
Woda w pociągach podlega regulacjom, które mają na celu zapewnienie jej odpowiedniej jakości. Przewoźnicy są zobowiązani do przestrzegania norm dotyczących czystości i bezpieczeństwa wody, co ma kluczowe znaczenie dla zdrowia pasażerów. Warto jednak pamiętać, że jakość wody może się różnić w zależności od przewoźnika oraz regionu, w którym odbywa się podróż.
Jakie są standardy dotyczące wody w pociągach?
Standardy dotyczące wody w pociągach są ustalane przez odpowiednie organy regulacyjne, które dbają o to, aby woda spełniała określone normy jakości. W Polsce, na przykład, woda w pociągach musi być zgodna z normami sanitarnymi, które określają maksymalne dopuszczalne stężenia zanieczyszczeń. W przypadku pociągów Amtrak, standardy te są również rygorystycznie przestrzegane, co zapewnia pasażerom pewność co do jakości wody.
| Przewoźnik | Standardy jakości wody |
| Amtrak | Woda spełnia normy EPA, regularne testy jakości |
| PKP Intercity | Woda zgodna z normami sanitarno-epidemiologicznymi |
| Deutsche Bahn | Woda poddawana regularnym kontrolom jakości |
Czy woda z kranu w pociągach jest bezpieczna do picia?
Wiele osób zastanawia się, czy woda z kranu w pociągach jest bezpieczna do picia. Przewoźnicy, tacy jak Amtrak, regularnie przeprowadzają testy jakości wody, aby zapewnić, że spełnia ona normy sanitarno-epidemiologiczne. Woda ta jest zazwyczaj uznawana za zdatną do picia, jednak niektórzy pasażerowie sugerują, aby zachować ostrożność i unikać jej, zwłaszcza w czasach pandemii. Warto zatem być świadomym, że chociaż woda jest kontrolowana, jej jakość może się różnić w zależności od trasy i warunków.
Władze zdrowotne zalecają, aby osoby z osłabionym układem odpornościowym lub alergiami mogły unikać picia wody z kranu w pociągach. W przypadku wątpliwości, zawsze lepiej jest zabrać ze sobą własną wodę, aby uniknąć potencjalnych problemów zdrowotnych. Pamiętaj, że bezpieczeństwo wody to nie tylko kwestia jej pochodzenia, ale także warunków, w jakich jest przechowywana i transportowana.
Potencjalne zagrożenia związane z piciem wody w pociągu
Chociaż woda w pociągach jest zazwyczaj uznawana za bezpieczną, istnieją pewne potencjalne zagrożenia związane z jej spożywaniem. Pasażerowie często zgłaszają obawy dotyczące jakości wody, zwłaszcza w kontekście długich podróży. Zdarza się, że woda może mieć nieprzyjemny zapach lub smak, co może wynikać z zanieczyszczeń lub niewłaściwego przechowywania. Warto zwrócić uwagę na te aspekty, aby uniknąć nieprzyjemnych niespodzianek podczas podróży.
Oprócz problemów z jakością, istnieją również obawy dotyczące higieny. W czasach pandemii, wiele osób obawia się, że woda w pociągach może być źródłem zakażeń. Dlatego ważne jest, aby być świadomym potencjalnych zagrożeń i podejmować odpowiednie środki ostrożności. Zawsze warto mieć ze sobą własną butelkę wody, aby zapewnić sobie odpowiednie nawodnienie bez ryzyka związanego z jakością wody w pociągu.
Jakie są opinie pasażerów o wodzie w pociągach?
Opinie pasażerów na temat wody w pociągach są zróżnicowane. Niektórzy podróżni twierdzą, że woda z kranu jest wystarczająco dobra i nie sprawia im problemów zdrowotnych. Inni jednak zgłaszają, że woda ma nieprzyjemny zapach lub smak, co może wynikać z nieodpowiedniego przechowywania lub zanieczyszczeń. Wiele osób zaleca zabranie własnej butelki wody, aby uniknąć nieprzyjemnych niespodzianek podczas podróży.
Warto również zauważyć, że opinie te mogą się różnić w zależności od trasy i przewoźnika. Pasażerowie korzystający z pociągów Amtrak często podkreślają, że woda w ich pociągach jest zdatna do picia, ale niektórzy sugerują, aby zachować ostrożność. Takie doświadczenia mogą być pomocne dla przyszłych podróżnych, którzy planują korzystać z usług kolejowych.
Jak pandemia wpłynęła na jakość wody w pociągach?
Pandemia COVID-19 znacząco wpłynęła na wiele aspektów podróży, w tym na jakość wody w pociągach. W odpowiedzi na obawy zdrowotne, przewoźnicy wprowadzili dodatkowe środki ostrożności, aby zapewnić bezpieczeństwo pasażerów. Wiele firm kolejowych, w tym Amtrak, zwiększyło częstotliwość testów wody oraz wprowadziło bardziej rygorystyczne procedury czyszczenia i dezynfekcji.
W rezultacie, pasażerowie mogą zauważyć poprawę jakości wody w pociągach. Niemniej jednak, niektórzy podróżni nadal zalecają ostrożność i zabranie własnej wody, aby uniknąć potencjalnych zagrożeń. Warto być świadomym, że zmiany w polityce dotyczącej jakości wody mogą się różnić w zależności od regionu i przewoźnika.
Czytaj więcej: Gdzie warto pojechać pociągiem? Odkryj najlepsze destynacje w Polsce

Co warto wiedzieć przed podróżą pociągiem?
Przed wyruszeniem w podróż pociągiem, warto zastanowić się nad kwestią wody i nawodnienia. Choć woda w pociągach jest zazwyczaj uznawana za zdatną do picia, niektórzy pasażerowie sugerują, aby zachować ostrożność i zabrać ze sobą własną butelkę wody. To rozwiązanie daje większe poczucie bezpieczeństwa, zwłaszcza w czasach pandemii, kiedy obawy zdrowotne są na czołowej pozycji. Posiadanie własnej wody pozwala uniknąć nieprzyjemnych niespodzianek związanych z jakością wody w pociągu.
Oprócz zabrania własnej butelki, warto również zwrócić uwagę na dostępne alternatywy. W pociągach często oferowane są różne napoje, takie jak woda butelkowana, soki czy napoje gazowane. Zawsze warto sprawdzić, co jest dostępne na pokładzie, aby zapewnić sobie odpowiednie nawodnienie podczas podróży. Posiadanie własnej wody oraz znajomość alternatywnych opcji to kluczowe elementy, które mogą znacząco poprawić komfort podróży.
Dlaczego warto zabrać własną wodę w podróż?
Podczas podróży pociągiem, zabranie własnej wody może przynieść wiele korzyści. Przede wszystkim, posiadanie własnej butelki z wodą pozwala uniknąć potencjalnych problemów związanych z jakością wody w pociągach. Choć woda z kranu jest zazwyczaj uznawana za zdatną do picia, niektórzy pasażerowie mogą odczuwać niepewność co do jej smaku czy zapachu. Posiadając własną wodę, można mieć pewność, że jest ona świeża i odpowiada naszym preferencjom.
Dodatkowo, zabranie własnej wody jest bardziej ekonomiczne. Wiele stacji kolejowych oraz pociągów oferuje napoje w sprzedaży, które mogą być znacznie droższe niż woda, którą można napełnić w domu. Warto również pamiętać, że odpowiednie nawodnienie jest kluczowe dla komfortu podróży, zwłaszcza podczas długich tras. Dlatego warto zadbać o to, aby mieć przy sobie odpowiednią ilość wody na czas podróży.
Jakie alternatywy są dostępne dla wody w pociągu?
Podczas podróży pociągiem, pasażerowie mają do wyboru różne alternatywy dla wody. Oprócz wody z kranu, w wielu pociągach dostępne są napoje butelkowane, soki oraz napoje gazowane. Warto zwrócić uwagę na dostępne opcje, aby zapewnić sobie odpowiednie nawodnienie. W niektórych pociągach, jak Amtrak, można również zamówić napoje przez obsługę pokładową.
- Woda butelkowana (marki takie jak Żywiec Zdrój, Nałęczowianka)
- Soki owocowe (np. Tymbark, Hellena)
- Napoje gazowane (np. Coca-Cola, Sprite)
Jak skutecznie przygotować się do podróży pociągiem z własną wodą?
Przygotowując się do podróży pociągiem, warto pomyśleć o efektywnym planowaniu nawodnienia. Oprócz zabrania własnej butelki z wodą, można zainwestować w inteligentną butelkę, która przypomina o regularnym piciu i monitoruje spożycie wody. Takie urządzenia często mają wbudowane funkcje, które pozwalają na śledzenie nawodnienia w aplikacji mobilnej, co może być szczególnie przydatne podczas długich tras, gdzie dostęp do wody może być ograniczony.
Dodatkowo, warto rozważyć zakup filtrów do wody, które można używać w podróży. Dzięki nim, można napełniać butelkę wodą z kranu w pociągu, mając pewność, że zostanie ona przefiltrowana i oczyszczona z potencjalnych zanieczyszczeń. To nie tylko podnosi jakość spożywanej wody, ale również zmniejsza ilość plastiku, co jest korzystne dla środowiska. Takie podejście do nawodnienia podczas podróży może znacząco poprawić komfort i bezpieczeństwo podróżnych.